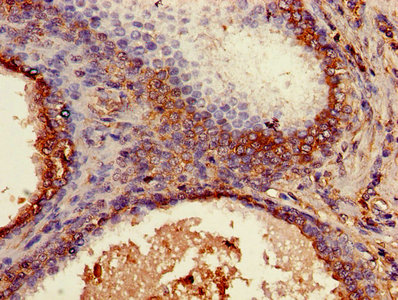
CSB-PA002486YA01HU

B2M
B2M,全名為Beta-2-microglobulin(β2-微球蛋白),是一種在所有有核細胞中表達的蛋白質,與MHC I類分子結合,參與抗原呈遞給免疫系統。B2M蛋白有多種別名,如LY-M11、BETA-2 MICROGLOBULIN等。它在免疫系統中發揮著重要作用,與多種疾病相關,包括多發性骨髓瘤、淋巴瘤和結直腸癌。在藥物研發方面,B2M蛋白成為治療這些疾病的新靶點,相關研究正在不斷進展中。
熱銷產品
B2M Antibody (CSB-PA002486YA01HU)
驗證數據

Western blot
All lanes: B2M antibody at 2µg/ml
Lane 1: A431 whole cell lysate
Lane 2: Mouse lung tissue
Secondary
Goat polyclonal to rabbit IgG at 1/10000 dilution
Predicted band size: 14 kDa
Observed band size: 14 kDa
Immunohistochemistry of paraffin-embedded human prostate cancer using CSB-PA002486YA01HU at dilution of 1:100

Immunohistochemistry of paraffin-embedded human lung cancer using CSB-PA002486YA01HU at dilution of 1:100
Human β2-microglobulin,BMG/β2-MG ELISA Kit (CSB-E04883h)
驗證數據

貨號:CSB-E04883h
規格:96T/48T
靈敏度:0.039 μg/mL
檢測范圍:0.039 μg/mL-10 μg/mL
These standard curves are provided for demonstration only. A standard curve should be generated for each set of samples assayed.
B2M Antibodies
B2M for Homo sapiens (Human)
| 產品貨號 | 產品名稱 | 種屬反應性 | 應用類型 |
|---|---|---|---|
| CSB-PA05786A0Rb | B2M Antibody | Human, Mouse | ELISA, WB |
| CSB-PA05786B0Rb | B2M Antibody, HRP conjugated | Human | ELISA |
| CSB-PA05786C0Rb | B2M Antibody, FITC conjugated | Human | |
| CSB-PA05786D0Rb | B2M Antibody, Biotin conjugated | Human | ELISA |
| CSB-PA002486YC01HU | B2M Antibody, FITC conjugated | Human | |
| CSB-PA002486YA01HU | B2M Antibody | Human, Mouse | ELISA, WB, IHC |
| CSB-PA193585 | B2M Antibody | Human | ELISA,WB |
| CSB-PA791042 | B2M Antibody | Human | ELISA,WB,IHC |
| CSB-PA002486GA01HU | B2M Antibody | Human,Mouse,Rat | ELISA,FC,IF,IHC,WB |
B2M for Mus musculus (Mouse)
| 產品貨號 | 產品名稱 | 種屬反應性 | 應用類型 |
|---|---|---|---|
| CSB-PA002486LA01MO | B2m Antibody | Mouse | ELISA, WB, IHC |
B2M Proteins
B2M Proteins for Gallus gallus (Chicken)
| 產品貨號 | 產品名稱 | 來源 |
|---|---|---|
| CSB-YP002486CH CSB-EP002486CH CSB-BP002486CH CSB-MP002486CH CSB-EP002486CH-B |
Recombinant Chicken Beta-2-microglobulin (B2M) | Yeast E.coli Baculovirus Mammalian cell In Vivo Biotinylation in E.coli |
B2M Proteins for Canis familiaris (Dog) (Canis lupus familiaris)
| 產品貨號 | 產品名稱 | 來源 |
|---|---|---|
| CSB-YP002486DO CSB-EP002486DO CSB-BP002486DO CSB-MP002486DO CSB-EP002486DO-B |
Recombinant Dog Beta-2-microglobulin (B2M) | Yeast E.coli Baculovirus Mammalian cell In Vivo Biotinylation in E.coli |
B2M Proteins for Equus caballus (Horse)
| 產品貨號 | 產品名稱 | 來源 |
|---|---|---|
| CSB-YP002486HO CSB-EP002486HO CSB-BP002486HO CSB-MP002486HO CSB-EP002486HO-B |
Recombinant Horse Beta-2-microglobulin (B2M) | Yeast E.coli Baculovirus Mammalian cell In Vivo Biotinylation in E.coli |
B2M Proteins for Cavia porcellus (Guinea pig)
| 產品貨號 | 產品名稱 | 來源 |
|---|---|---|
| CSB-YP002486GU CSB-EP002486GU CSB-BP002486GU CSB-MP002486GU CSB-EP002486GU-B |
Recombinant Guinea pig Beta-2-microglobulin (B2M) | Yeast E.coli Baculovirus Mammalian cell In Vivo Biotinylation in E.coli |
B2M Proteins for Mus musculus (Mouse)
| 產品貨號 | 產品名稱 | 來源 |
|---|---|---|
| CSB-YP002486MO CSB-EP002486MO CSB-BP002486MO CSB-MP002486MO CSB-EP002486MO-B |
Recombinant Mouse Beta-2-microglobulin (B2m) | Yeast E.coli Baculovirus Mammalian cell In Vivo Biotinylation in E.coli |
B2M Proteins for Oryctolagus cuniculus (Rabbit)
| 產品貨號 | 產品名稱 | 來源 |
|---|---|---|
| CSB-YP002486RB CSB-EP002486RB CSB-BP002486RB CSB-MP002486RB CSB-EP002486RB-B |
Recombinant Rabbit Beta-2-microglobulin (B2M) | Yeast E.coli Baculovirus Mammalian cell In Vivo Biotinylation in E.coli |
B2M Proteins for Bos taurus (Bovine)
| 產品貨號 | 產品名稱 | 來源 |
|---|---|---|
| CSB-YP002486BO CSB-EP002486BO CSB-BP002486BO CSB-MP002486BO CSB-EP002486BO-B |
Recombinant Bovine Beta-2-microglobulin (B2M) | Yeast E.coli Baculovirus Mammalian cell In Vivo Biotinylation in E.coli |
B2M Proteins for Ictalurus punctatus (Channel catfish)
| 產品貨號 | 產品名稱 | 來源 |
|---|---|---|
| CSB-YP002486ILX CSB-EP002486ILX CSB-BP002486ILX CSB-MP002486ILX CSB-EP002486ILX-B |
Recombinant Ictalurus punctatus Beta-2-microglobulin (b2m) | Yeast E.coli Baculovirus Mammalian cell In Vivo Biotinylation in E.coli |
B2M Proteins for Leontopithecus chrysopygus (Gold-and-black lion tamarin)
| 產品貨號 | 產品名稱 | 來源 |
|---|---|---|
| CSB-YP002486LOM CSB-EP002486LOM CSB-BP002486LOM CSB-MP002486LOM CSB-EP002486LOM-B |
Recombinant Leontopithecus chrysopygus Beta-2-microglobulin (B2M) | Yeast E.coli Baculovirus Mammalian cell In Vivo Biotinylation in E.coli |
B2M Proteins for Pithecia irrorata (Gray monk saki)
| 產品貨號 | 產品名稱 | 來源 |
|---|---|---|
| CSB-YP002486EWF CSB-EP002486EWF CSB-BP002486EWF CSB-MP002486EWF CSB-EP002486EWF-B |
Recombinant Pithecia irrorata Beta-2-microglobulin (B2M) | Yeast E.coli Baculovirus Mammalian cell In Vivo Biotinylation in E.coli |
B2M Proteins for Callithrix emiliae (Snethlage's marmoset) (Mico emiliae)
| 產品貨號 | 產品名稱 | 來源 |
|---|---|---|
| CSB-YP002486CYJ CSB-EP002486CYJ CSB-BP002486CYJ CSB-MP002486CYJ CSB-EP002486CYJ-B |
Recombinant Callithrix emiliae Beta-2-microglobulin (B2M) | Yeast E.coli Baculovirus Mammalian cell In Vivo Biotinylation in E.coli |
B2M Proteins for Callicebus personatus nigrifrons (Black-fronted titi)
| 產品貨號 | 產品名稱 | 來源 |
|---|---|---|
| CSB-YP002486CYF CSB-EP002486CYF CSB-BP002486CYF CSB-MP002486CYF CSB-EP002486CYF-B |
Recombinant Callicebus personatus nigrifrons Beta-2-microglobulin (B2M) | Yeast E.coli Baculovirus Mammalian cell In Vivo Biotinylation in E.coli |
B2M Proteins for Saimiri boliviensis boliviensis (Bolivian squirrel monkey)
| 產品貨號 | 產品名稱 | 來源 |
|---|---|---|
| CSB-YP002486SWC CSB-EP002486SWC CSB-BP002486SWC CSB-MP002486SWC CSB-EP002486SWC-B |
Recombinant Saimiri boliviensis boliviensis Beta-2-microglobulin (B2M) | Yeast E.coli Baculovirus Mammalian cell In Vivo Biotinylation in E.coli |
B2M Proteins for Callimico goeldii (Goeldi's marmoset)
| 產品貨號 | 產品名稱 | 來源 |
|---|---|---|
| CSB-YP002486CYI CSB-EP002486CYI CSB-BP002486CYI CSB-MP002486CYI CSB-EP002486CYI-B |
Recombinant Callimico goeldii Beta-2-microglobulin (B2M) | Yeast E.coli Baculovirus Mammalian cell In Vivo Biotinylation in E.coli |
B2M Proteins for Brachyteles arachnoides (Southern muriqui) (Woolly spider monkey)
| 產品貨號 | 產品名稱 | 來源 |
|---|---|---|
| CSB-YP002486BVU CSB-EP002486BVU CSB-BP002486BVU CSB-MP002486BVU CSB-EP002486BVU-B |
Recombinant Brachyteles arachnoides Beta-2-microglobulin (B2M) | Yeast E.coli Baculovirus Mammalian cell In Vivo Biotinylation in E.coli |
B2M Proteins for Chiropotes satanas (Black-bearded saki)
| 產品貨號 | 產品名稱 | 來源 |
|---|---|---|
| CSB-YP002486DRX CSB-EP002486DRX CSB-BP002486DRX CSB-MP002486DRX CSB-EP002486DRX-B |
Recombinant Chiropotes satanas Beta-2-microglobulin (B2M) | Yeast E.coli Baculovirus Mammalian cell In Vivo Biotinylation in E.coli |
B2M Proteins for Saguinus imperator (Emperor tamarin)
| 產品貨號 | 產品名稱 | 來源 |
|---|---|---|
| CSB-YP002486SVX CSB-EP002486SVX CSB-BP002486SVX CSB-MP002486SVX CSB-EP002486SVX-B |
Recombinant Saguinus imperator Beta-2-microglobulin (B2M) | Yeast E.coli Baculovirus Mammalian cell In Vivo Biotinylation in E.coli |
B2M Proteins for Lagothrix lagotricha (Common woolly monkey)
| 產品貨號 | 產品名稱 | 來源 |
|---|---|---|
| CSB-YP002486LNL CSB-EP002486LNL CSB-BP002486LNL CSB-MP002486LNL CSB-EP002486LNL-B |
Recombinant Lagothrix lagotricha Beta-2-microglobulin (B2M) | Yeast E.coli Baculovirus Mammalian cell In Vivo Biotinylation in E.coli |
B2M Proteins for Callicebus torquatus (Collared titi)
| 產品貨號 | 產品名稱 | 來源 |
|---|---|---|
| CSB-YP002486CYH CSB-EP002486CYH CSB-BP002486CYH CSB-MP002486CYH CSB-EP002486CYH-B |
Recombinant Callicebus torquatus Beta-2-microglobulin (B2M) | Yeast E.coli Baculovirus Mammalian cell In Vivo Biotinylation in E.coli |
B2M Proteins for Ateles paniscus (Black spider monkey)
| 產品貨號 | 產品名稱 | 來源 |
|---|---|---|
| CSB-YP002486DPI CSB-EP002486DPI CSB-BP002486DPI CSB-MP002486DPI CSB-EP002486DPI-B |
Recombinant Ateles paniscus Beta-2-microglobulin (B2M) | Yeast E.coli Baculovirus Mammalian cell In Vivo Biotinylation in E.coli |
B2M Proteins for Saguinus midas niger (Black-handed tamarin)
| 產品貨號 | 產品名稱 | 來源 |
|---|---|---|
| CSB-YP002486SVZ CSB-EP002486SVZ CSB-BP002486SVZ CSB-MP002486SVZ CSB-EP002486SVZ-B |
Recombinant Saguinus midas niger Beta-2-microglobulin (B2M) | Yeast E.coli Baculovirus Mammalian cell In Vivo Biotinylation in E.coli |
B2M Proteins for Alouatta seniculus (Red howler monkey)
| 產品貨號 | 產品名稱 | 來源 |
|---|---|---|
| CSB-YP002486AZU CSB-EP002486AZU CSB-BP002486AZU CSB-MP002486AZU CSB-EP002486AZU-B |
Recombinant Alouatta seniculus Beta-2-microglobulin (B2M) | Yeast E.coli Baculovirus Mammalian cell In Vivo Biotinylation in E.coli |
B2M Proteins for Callicebus hoffmannsi (Hoffmann's titi)
| 產品貨號 | 產品名稱 | 來源 |
|---|---|---|
| CSB-YP002486CYD CSB-EP002486CYD CSB-BP002486CYD CSB-MP002486CYD CSB-EP002486CYD-B |
Recombinant Callicebus hoffmannsi Beta-2-microglobulin (B2M) | Yeast E.coli Baculovirus Mammalian cell In Vivo Biotinylation in E.coli |
B2M Proteins for Cebuella pygmaea (Pygmy marmoset) (Callithrix pygmaea)
| 產品貨號 | 產品名稱 | 來源 |
|---|---|---|
| CSB-YP002486DQT CSB-EP002486DQT CSB-BP002486DQT CSB-MP002486DQT CSB-EP002486DQT-B |
Recombinant Cebuella pygmaea Beta-2-microglobulin (B2M) | Yeast E.coli Baculovirus Mammalian cell In Vivo Biotinylation in E.coli |
B2M Proteins for Callicebus personatus personatus (Masked titi)
| 產品貨號 | 產品名稱 | 來源 |
|---|---|---|
| CSB-YP002486CYG CSB-EP002486CYG CSB-BP002486CYG CSB-MP002486CYG CSB-EP002486CYG-B |
Recombinant Callicebus personatus personatus Beta-2-microglobulin (B2M) | Yeast E.coli Baculovirus Mammalian cell In Vivo Biotinylation in E.coli |
B2M Proteins for Cacajao melanocephalus (Black-headed uakari)
| 產品貨號 | 產品名稱 | 來源 |
|---|---|---|
| CSB-YP002486CXW CSB-EP002486CXW CSB-BP002486CXW CSB-MP002486CXW CSB-EP002486CXW-B |
Recombinant Cacajao melanocephalus Beta-2-microglobulin (B2M) | Yeast E.coli Baculovirus Mammalian cell In Vivo Biotinylation in E.coli |
B2M Proteins for Aotus azarae (Southern owl monkey) (Aotus azarai)
| 產品貨號 | 產品名稱 | 來源 |
|---|---|---|
| CSB-YP002486DNH CSB-EP002486DNH CSB-BP002486DNH CSB-MP002486DNH CSB-EP002486DNH-B |
Recombinant Aotus azarae Beta-2-microglobulin (B2M) | Yeast E.coli Baculovirus Mammalian cell In Vivo Biotinylation in E.coli |
B2M Proteins for Pongo pygmaeus (Bornean orangutan)
| 產品貨號 | 產品名稱 | 來源 |
|---|---|---|
| CSB-YP002486EXP CSB-EP002486EXP CSB-BP002486EXP CSB-MP002486EXP CSB-EP002486EXP-B |
Recombinant Pongo pygmaeus Beta-2-microglobulin (B2M) | Yeast E.coli Baculovirus Mammalian cell In Vivo Biotinylation in E.coli |
B2M Proteins for Meleagris gallopavo (Common turkey)
| 產品貨號 | 產品名稱 | 來源 |
|---|---|---|
| CSB-YP002486MQV CSB-EP002486MQV CSB-BP002486MQV CSB-MP002486MQV CSB-EP002486MQV-B |
Recombinant Meleagris gallopavo Beta-2-microglobulin (B2M) | Yeast E.coli Baculovirus Mammalian cell In Vivo Biotinylation in E.coli |
B2M Proteins for Mesocricetus auratus (Golden hamster)
| 產品貨號 | 產品名稱 | 來源 |
|---|---|---|
| CSB-YP002486MRG CSB-EP002486MRG CSB-BP002486MRG CSB-MP002486MRG CSB-EP002486MRG-B |
Recombinant Mesocricetus auratus Beta-2-microglobulin (B2M) | Yeast E.coli Baculovirus Mammalian cell In Vivo Biotinylation in E.coli |
B2M Proteins for Mus cervicolor (Fawn-colored mouse)
| 產品貨號 | 產品名稱 | 來源 |
|---|---|---|
| CSB-YP002486MKP CSB-EP002486MKP CSB-BP002486MKP CSB-MP002486MKP CSB-EP002486MKP-B |
Recombinant Mus cervicolor Beta-2-microglobulin (B2m) | Yeast E.coli Baculovirus Mammalian cell In Vivo Biotinylation in E.coli |
B2M Proteins for Saguinus oedipus (Cotton-top tamarin)
| 產品貨號 | 產品名稱 | 來源 |
|---|---|---|
| CSB-YP002486SWB CSB-EP002486SWB CSB-BP002486SWB CSB-MP002486SWB CSB-EP002486SWB-B |
Recombinant Saguinus oedipus Beta-2-microglobulin (B2M) | Yeast E.coli Baculovirus Mammalian cell In Vivo Biotinylation in E.coli |
B2M Proteins for Labeobarbus intermedius (Lake tana barbels) (Barbus intermedius)
| 產品貨號 | 產品名稱 | 來源 |
|---|---|---|
| CSB-YP002486LAB CSB-EP002486LAB CSB-BP002486LAB CSB-MP002486LAB CSB-EP002486LAB-B |
Recombinant Labeobarbus intermedius Beta-2-microglobulin (b2m) | Yeast E.coli Baculovirus Mammalian cell In Vivo Biotinylation in E.coli |
B2M Proteins for Mus caroli (Ryukyu mouse) (Ricefield mouse)
| 產品貨號 | 產品名稱 | 來源 |
|---|---|---|
| CSB-YP002486MUU CSB-EP002486MUU CSB-BP002486MUU CSB-MP002486MUU CSB-EP002486MUU-B |
Recombinant Mus caroli Beta-2-microglobulin (B2m) | Yeast E.coli Baculovirus Mammalian cell In Vivo Biotinylation in E.coli |
B2M Proteins for Callithrix aurita (White-eared marmoset) (Buffy-eared marmoset)
| 產品貨號 | 產品名稱 | 來源 |
|---|---|---|
| CSB-YP002486CBB CSB-EP002486CBB CSB-BP002486CBB CSB-MP002486CBB CSB-EP002486CBB-B |
Recombinant Callithrix aurita Beta-2-microglobulin (B2M) | Yeast E.coli Baculovirus Mammalian cell In Vivo Biotinylation in E.coli |
B2M Proteins for Aotus nancymaae (Ma's night monkey)
| 產品貨號 | 產品名稱 | 來源 |
|---|---|---|
| CSB-YP002486AUV CSB-EP002486AUV CSB-BP002486AUV CSB-MP002486AUV CSB-EP002486AUV-B |
Recombinant Aotus nancymaae Beta-2-microglobulin (B2M) | Yeast E.coli Baculovirus Mammalian cell In Vivo Biotinylation in E.coli |
B2M Proteins for Saguinus bicolor bicolor (Pied bare-faced tamarin)
| 產品貨號 | 產品名稱 | 來源 |
|---|---|---|
| CSB-YP002486SAP CSB-EP002486SAP CSB-BP002486SAP CSB-MP002486SAP CSB-EP002486SAP-B |
Recombinant Saguinus bicolor bicolor Beta-2-microglobulin (B2M) | Yeast E.coli Baculovirus Mammalian cell In Vivo Biotinylation in E.coli |
B2M Proteins for Saguinus mystax (Moustached tamarin)
| 產品貨號 | 產品名稱 | 來源 |
|---|---|---|
| CSB-YP002486SWA CSB-EP002486SWA CSB-BP002486SWA CSB-MP002486SWA CSB-EP002486SWA-B |
Recombinant Saguinus mystax Beta-2-microglobulin (B2M) | Yeast E.coli Baculovirus Mammalian cell In Vivo Biotinylation in E.coli |
B2M Proteins for Gorilla gorilla gorilla (Lowland gorilla)
| 產品貨號 | 產品名稱 | 來源 |
|---|---|---|
| CSB-YP002486GGZ CSB-EP002486GGZ CSB-BP002486GGZ CSB-MP002486GGZ CSB-EP002486GGZ-B |
Recombinant Gorilla gorilla gorilla Beta-2-microglobulin (B2M) | Yeast E.coli Baculovirus Mammalian cell In Vivo Biotinylation in E.coli |
B2M Proteins for Callithrix jacchus (White-tufted-ear marmoset)
| 產品貨號 | 產品名稱 | 來源 |
|---|---|---|
| CSB-YP002486CYL CSB-EP002486CYL CSB-BP002486CYL CSB-MP002486CYL CSB-EP002486CYL-B |
Recombinant Callithrix jacchus Beta-2-microglobulin (B2M) | Yeast E.coli Baculovirus Mammalian cell In Vivo Biotinylation in E.coli |
B2M Proteins for Cebus albifrons (White-fronted capuchin)
| 產品貨號 | 產品名稱 | 來源 |
|---|---|---|
| CSB-YP002486CFJ CSB-EP002486CFJ CSB-BP002486CFJ CSB-MP002486CFJ CSB-EP002486CFJ-B |
Recombinant Cebus albifrons Beta-2-microglobulin (B2M) | Yeast E.coli Baculovirus Mammalian cell In Vivo Biotinylation in E.coli |
B2M Proteins for Saguinus bicolor martinsi (Martin's tamarin)
| 產品貨號 | 產品名稱 | 來源 |
|---|---|---|
| CSB-YP002486SAQ CSB-EP002486SAQ CSB-BP002486SAQ CSB-MP002486SAQ CSB-EP002486SAQ-B |
Recombinant Saguinus bicolor martinsi Beta-2-microglobulin (B2M) | Yeast E.coli Baculovirus Mammalian cell In Vivo Biotinylation in E.coli |
B2M Proteins for Callithrix kuhlii (Wied's black-tufted-ear marmoset)
| 產品貨號 | 產品名稱 | 來源 |
|---|---|---|
| CSB-YP002486CBC CSB-EP002486CBC CSB-BP002486CBC CSB-MP002486CBC CSB-EP002486CBC-B |
Recombinant Callithrix kuhlii Beta-2-microglobulin (B2M) | Yeast E.coli Baculovirus Mammalian cell In Vivo Biotinylation in E.coli |
B2M Proteins for Cebus apella (Brown-capped capuchin)
| 產品貨號 | 產品名稱 | 來源 |
|---|---|---|
| CSB-YP002486DQU CSB-EP002486DQU CSB-BP002486DQU CSB-MP002486DQU CSB-EP002486DQU-B |
Recombinant Cebus apella Beta-2-microglobulin (B2M) | Yeast E.coli Baculovirus Mammalian cell In Vivo Biotinylation in E.coli |
B2M Proteins for Pan troglodytes (Chimpanzee)
| 產品貨號 | 產品名稱 | 來源 |
|---|---|---|
| CSB-YP002486EQV CSB-EP002486EQV CSB-BP002486EQV CSB-MP002486EQV CSB-EP002486EQV-B |
Recombinant Pan troglodytes Beta-2-microglobulin (B2M) | Yeast E.coli Baculovirus Mammalian cell In Vivo Biotinylation in E.coli |
B2M Proteins for Aotus lemurinus (Northern gray-necked night monkey)
| 產品貨號 | 產品名稱 | 來源 |
|---|---|---|
| CSB-YP002486ALX CSB-EP002486ALX CSB-BP002486ALX CSB-MP002486ALX CSB-EP002486ALX-B |
Recombinant Aotus lemurinus Beta-2-microglobulin (B2M) | Yeast E.coli Baculovirus Mammalian cell In Vivo Biotinylation in E.coli |
B2M Proteins for Cebus olivaceus (Weeper capuchin)
| 產品貨號 | 產品名稱 | 來源 |
|---|---|---|
| CSB-YP002486CFL CSB-EP002486CFL CSB-BP002486CFL CSB-MP002486CFL CSB-EP002486CFL-B |
Recombinant Cebus olivaceus Beta-2-microglobulin (B2M) | Yeast E.coli Baculovirus Mammalian cell In Vivo Biotinylation in E.coli |
B2M Proteins for Saguinus midas midas (Golden-handed tamarin)
| 產品貨號 | 產品名稱 | 來源 |
|---|---|---|
| CSB-YP002486SAT CSB-EP002486SAT CSB-BP002486SAT CSB-MP002486SAT CSB-EP002486SAT-B |
Recombinant Saguinus midas midas Beta-2-microglobulin (B2M) | Yeast E.coli Baculovirus Mammalian cell In Vivo Biotinylation in E.coli |
B2M Proteins for Rattus norvegicus (Rat)
| 產品貨號 | 產品名稱 | 來源 |
|---|---|---|
| CSB-YP002486RA CSB-EP002486RA CSB-BP002486RA CSB-MP002486RA CSB-EP002486RA-B |
Recombinant Rat Beta-2-microglobulin (B2m) | Yeast E.coli Baculovirus Mammalian cell In Vivo Biotinylation in E.coli |
B2M Proteins for Felis catus (Cat) (Felis silvestris catus)
| 產品貨號 | 產品名稱 | 來源 |
|---|---|---|
| CSB-YP002486CA CSB-BP002486CA CSB-EP002486CA-B |
Recombinant Cat Beta-2-microglobulin (B2M) | Yeast Baculovirus In Vivo Biotinylation in E.coli |
B2M Proteins for Saimiri sciureus (Common squirrel monkey)
| 產品貨號 | 產品名稱 | 來源 |
|---|---|---|
| CSB-YP002486SWD CSB-EP002486SWD CSB-BP002486SWD CSB-MP002486SWD CSB-EP002486SWD-B |
Recombinant Saimiri sciureus Beta-2-microglobulin (B2M) | Yeast E.coli Baculovirus Mammalian cell In Vivo Biotinylation in E.coli |
B2M Proteins for Chlorocebus aethiops (Green monkey) (Cercopithecus aethiops)
| 產品貨號 | 產品名稱 | 來源 |
|---|---|---|
| CSB-YP002486DSU CSB-EP002486DSU CSB-BP002486DSU CSB-MP002486DSU CSB-EP002486DSU-B |
Recombinant Chlorocebus aethiops Beta-2-microglobulin (B2M) | Yeast E.coli Baculovirus Mammalian cell In Vivo Biotinylation in E.coli |
B2M Proteins for Callithrix penicillata (Black-pencilled marmoset)
| 產品貨號 | 產品名稱 | 來源 |
|---|---|---|
| CSB-YP002486CAAC CSB-EP002486CAAC CSB-BP002486CAAC CSB-MP002486CAAC CSB-EP002486CAAC-B |
Recombinant Callithrix penicillata Beta-2-microglobulin (B2M) | Yeast E.coli Baculovirus Mammalian cell In Vivo Biotinylation in E.coli |
B2M Proteins for Papio anubis (Olive baboon)
| 產品貨號 | 產品名稱 | 來源 |
|---|---|---|
| CSB-YP002486ERI CSB-EP002486ERI CSB-BP002486ERI CSB-MP002486ERI CSB-EP002486ERI-B |
Recombinant Papio anubis Beta-2-microglobulin (B2M) | Yeast E.coli Baculovirus Mammalian cell In Vivo Biotinylation in E.coli |
B2M Proteins for Macaca mulatta (Rhesus macaque)
| 產品貨號 | 產品名稱 | 來源 |
|---|---|---|
| CSB-YP002486MOW CSB-EP002486MOW CSB-BP002486MOW CSB-MP002486MOW CSB-EP002486MOW-B |
Recombinant Macaca mulatta Beta-2-microglobulin (B2M) | Yeast E.coli Baculovirus Mammalian cell In Vivo Biotinylation in E.coli |
B2M Proteins for Callicebus moloch (Dusky titi monkey)
| 產品貨號 | 產品名稱 | 來源 |
|---|---|---|
| CSB-YP002486CYE CSB-EP002486CYE CSB-BP002486CYE CSB-MP002486CYE CSB-EP002486CYE-B |
Recombinant Callicebus moloch Beta-2-microglobulin (B2M) | Yeast E.coli Baculovirus Mammalian cell In Vivo Biotinylation in E.coli |
B2M Proteins for Ovis aries (Sheep)
| 產品貨號 | 產品名稱 | 來源 |
|---|---|---|
| CSB-YP002486SH CSB-BP002486SH CSB-MP002486SH CSB-EP002486SH-B |
Recombinant Sheep Beta-2-microglobulin (B2M) | Yeast Baculovirus Mammalian cell In Vivo Biotinylation in E.coli |
| CSB-EP002486SH | Recombinant Sheep Beta-2-microglobulin (B2M) | E.coli |
B2M Proteins for Callithrix humeralifera (Tassel-eared marmoset)
| 產品貨號 | 產品名稱 | 來源 |
|---|---|---|
| CSB-YP002486CAAE CSB-EP002486CAAE CSB-BP002486CAAE CSB-MP002486CAAE CSB-EP002486CAAE-B |
Recombinant Callithrix humeralifera Beta-2-microglobulin (B2M) | Yeast E.coli Baculovirus Mammalian cell In Vivo Biotinylation in E.coli |
B2M Proteins for Saimiri ustus (Golden-backed squirrel monkey)
| 產品貨號 | 產品名稱 | 來源 |
|---|---|---|
| CSB-YP002486SWE CSB-EP002486SWE CSB-BP002486SWE CSB-MP002486SWE CSB-EP002486SWE-B |
Recombinant Saimiri ustus Beta-2-microglobulin (B2M) | Yeast E.coli Baculovirus Mammalian cell In Vivo Biotinylation in E.coli |
B2M Proteins for Monodelphis domestica (Gray short-tailed opossum)
| 產品貨號 | 產品名稱 | 來源 |
|---|---|---|
| CSB-YP002486MUE CSB-EP002486MUE CSB-BP002486MUE CSB-MP002486MUE CSB-EP002486MUE-B |
Recombinant Monodelphis domestica Beta-2-microglobulin (B2M) | Yeast E.coli Baculovirus Mammalian cell In Vivo Biotinylation in E.coli |
B2M Proteins for Equus burchellii antiquorum (Damara zebra) (Chapman zebra)
| 產品貨號 | 產品名稱 | 來源 |
|---|---|---|
| CSB-YP002486EAAC CSB-EP002486EAAC CSB-BP002486EAAC CSB-MP002486EAAC CSB-EP002486EAAC-B |
Recombinant Equus burchellii antiquorum Beta-2-microglobulin (B2M) | Yeast E.coli Baculovirus Mammalian cell In Vivo Biotinylation in E.coli |
B2M Proteins for Ornithorhynchus anatinus (Duckbill platypus)
| 產品貨號 | 產品名稱 | 來源 |
|---|---|---|
| CSB-YP002486OEX CSB-EP002486OEX CSB-BP002486OEX CSB-MP002486OEX CSB-EP002486OEX-B |
Recombinant Ornithorhynchus anatinus Beta-2-microglobulin (B2M) | Yeast E.coli Baculovirus Mammalian cell In Vivo Biotinylation in E.coli |
B2M Proteins for Equus asinus (Donkey)
| 產品貨號 | 產品名稱 | 來源 |
|---|---|---|
| CSB-YP002486DK CSB-EP002486DK CSB-BP002486DK CSB-MP002486DK CSB-EP002486DK-B |
Recombinant Donkey Beta-2-microglobulin (B2M) | Yeast E.coli Baculovirus Mammalian cell In Vivo Biotinylation in E.coli |
B2M Proteins for Equus grevyi (Grevy's zebra)
| 產品貨號 | 產品名稱 | 來源 |
|---|---|---|
| CSB-YP002486EJB CSB-EP002486EJB CSB-BP002486EJB CSB-MP002486EJB CSB-EP002486EJB-B |
Recombinant Equus grevyi Beta-2-microglobulin (B2M) | Yeast E.coli Baculovirus Mammalian cell In Vivo Biotinylation in E.coli |
B2M Proteins for Tachyglossus aculeatus aculeatus (Australian echidna)
| 產品貨號 | 產品名稱 | 來源 |
|---|---|---|
| CSB-YP002486TKU CSB-EP002486TKU CSB-BP002486TKU CSB-MP002486TKU CSB-EP002486TKU-B |
Recombinant Tachyglossus aculeatus aculeatus Beta-2-microglobulin (B2M) | Yeast E.coli Baculovirus Mammalian cell In Vivo Biotinylation in E.coli |
B2M Proteins for Paralichthys olivaceus (Japanese flounder) (Hippoglossus olivaceus)
| 產品貨號 | 產品名稱 | 來源 |
|---|---|---|
| CSB-YP002486ERT CSB-EP002486ERT CSB-BP002486ERT CSB-MP002486ERT CSB-EP002486ERT-B |
Recombinant Paralichthys olivaceus Beta-2-microglobulin (b2m) | Yeast E.coli Baculovirus Mammalian cell In Vivo Biotinylation in E.coli |
B2M Proteins for Raja eglanteria (Clearnose skate)
| 產品貨號 | 產品名稱 | 來源 |
|---|---|---|
| CSB-YP002486RAAE CSB-EP002486RAAE CSB-BP002486RAAE CSB-MP002486RAAE CSB-EP002486RAAE-B |
Recombinant Raja eglanteria Beta-2-microglobulin (b2m) | Yeast E.coli Baculovirus Mammalian cell In Vivo Biotinylation in E.coli |
B2M Proteins for Sigmodon hispidus (Hispid cotton rat)
| 產品貨號 | 產品名稱 | 來源 |
|---|---|---|
| CSB-YP002486SZK CSB-EP002486SZK CSB-BP002486SZK CSB-MP002486SZK CSB-EP002486SZK-B |
Recombinant Sigmodon hispidus Beta-2-microglobulin (B2M) | Yeast E.coli Baculovirus Mammalian cell In Vivo Biotinylation in E.coli |
B2M Proteins for Macaca fascicularis (Crab-eating macaque) (Cynomolgus monkey)
| 產品貨號 | 產品名稱 | 來源 |
|---|---|---|
| CSB-YP002486MOV CSB-EP002486MOV CSB-BP002486MOV CSB-MP002486MOV CSB-EP002486MOV-B |
Recombinant Macaca fascicularis Beta-2-microglobulin (B2M) | Yeast E.coli Baculovirus Mammalian cell In Vivo Biotinylation in E.coli |
B2M Proteins for Trichosurus vulpecula (Brush-tailed possum)
| 產品貨號 | 產品名稱 | 來源 |
|---|---|---|
| CSB-YP002486TQG CSB-EP002486TQG CSB-BP002486TQG CSB-MP002486TQG CSB-EP002486TQG-B |
Recombinant Trichosurus vulpecula Beta-2-microglobulin (B2M) | Yeast E.coli Baculovirus Mammalian cell In Vivo Biotinylation in E.coli |
B2M Proteins for Xenopus laevis (African clawed frog)
| 產品貨號 | 產品名稱 | 來源 |
|---|---|---|
| CSB-YP002486XBE CSB-EP002486XBE CSB-BP002486XBE CSB-MP002486XBE CSB-EP002486XBE-B |
Recombinant Xenopus laevis Beta-2-microglobulin (b2m) | Yeast E.coli Baculovirus Mammalian cell In Vivo Biotinylation in E.coli |
B2M Proteins for Saguinus fuscicollis (Brown-headed tamarin)
| 產品貨號 | 產品名稱 | 來源 |
|---|---|---|
| CSB-YP002486SAR CSB-EP002486SAR CSB-BP002486SAR CSB-MP002486SAR CSB-EP002486SAR-B |
Recombinant Saguinus fuscicollis Beta-2-microglobulin (B2M) | Yeast E.coli Baculovirus Mammalian cell In Vivo Biotinylation in E.coli |
B2M Proteins for Acipenser baerii (Siberian sturgeon)
| 產品貨號 | 產品名稱 | 來源 |
|---|---|---|
| CSB-YP002486AAAJ CSB-EP002486AAAJ CSB-BP002486AAAJ CSB-MP002486AAAJ CSB-EP002486AAAJ-B |
Recombinant Acipenser baerii Beta-2-microglobulin (b2m) | Yeast E.coli Baculovirus Mammalian cell In Vivo Biotinylation in E.coli |
B2M Proteins for Cricetulus griseus (Chinese hamster) (Cricetulus barabensis griseus)
| 產品貨號 | 產品名稱 | 來源 |
|---|---|---|
| CSB-YP002486DXU CSB-EP002486DXU CSB-BP002486DXU CSB-MP002486DXU CSB-EP002486DXU-B |
Recombinant Cricetulus griseus Beta-2-microglobulin (B2M) | Yeast E.coli Baculovirus Mammalian cell In Vivo Biotinylation in E.coli |
B2M ELISA Kit
B2M ELISA Kit for Canis lupus familiaris (Dog) (Canis familiaris)
| 產品貨號 | 產品名稱 | 樣本類型 | 靈敏度 |
|---|---|---|---|
| CSB-E13768c | Dog β2-microglobulin,BMG/β2-MG ELISA Kit | serum, plasma, tissue homogenates | 0.2 μg/mL |
B2M ELISA Kit for Homo sapiens (Human)
| 產品貨號 | 產品名稱 | 樣本類型 | 靈敏度 |
|---|---|---|---|
| CSB-E04883h | Human β2-microglobulin,BMG/β2-MG ELISA Kit | serum, urine | 0.039 μg/mL |
B2M ELISA Kit for Mus musculus (Mouse)
| 產品貨號 | 產品名稱 | 樣本類型 | 靈敏度 |
|---|---|---|---|
| CSB-E13053m | Mouse β2-microglobulin,BMG/β2-MG ELISA Kit | serum, plasma, urine, tissue homogenates | 0.156 μg/ml. |
B2M ELISA Kit for Rattus norvegicus (Rat)
| 產品貨號 | 產品名稱 | 樣本類型 | 靈敏度 |
|---|---|---|---|
| CSB-E11298r | Rat β2-microglobulin,BMG/β2-MG ELISA Kit | serum, plasma, urine, tissue homogenates | 0.039 μg/mL |













